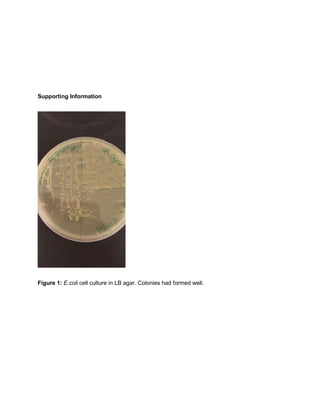
Supporting Information
Figure 1: E.coli cell culture in LB agar. Colonies had formed well.

This document summarizes research purifying the Streptomyces lividans endoglucanase CelB2 enzyme expressed in E. coli. CelB2 mutants were designed to be more thermally stable. CelB2 was expressed in E. coli BL21(DE3) as a fusion protein with maltose binding protein (MBP) to aid purification. CelB2 was purified using affinity chromatography on amylose resin, Factor Xa cleavage of MBP, and ion exchange chromatography. While CelB2 was purified, only low levels were recovered, suggesting further work is needed to improve CelB2 recovery and stability.

![Abstract
Cellulose, a plant polymer of D-glucose (bonded together by B-1,4-glucosyl linkages), is
the main component of plant cell walls and the most abundant protein in the world. It has largely
been considered as a possible alternative as a fuel source. We induce transformation of
mutants of Streptomyces lividans endoglucanase CelB2, an enzyme that hydrolyzes cellulose,
into the E.Coli strain BL21(DE3) in order to recover the endoglucanase enzyme, which can be
used to make cellulose a more viable alternative as a fuel source. The CelB2 mutant has amino
acid residues that are substituted in order to make a more thermally stable enzyme by making
the protein into an uncharged/neutral molecule. The E.Coli strain BL21(DE3) is better suitable
for transformation and protein expression and will upscale the amount of protein recovered. We
hypothesize that CelB2 will be recovered and the specific activity will increase several fold as
the protein is purified. We express CelB2 as His6MBPCelB2 fusion in order to separate the
enzyme from all other proteins from the cell by the use of amylose affinity chromatography. We
use Factor Xa, a protease, to cleave MBP from CelB2, and then use an Anion-Exchange
column (DEAE Sepharose) to further purify CelB2 from the solution. We use an activity assay
along with SDS-PAGE to measure and track the presence and concentration of CelB2. We use
the Beer-Lambert law to calculate [CelB2] to be 2.286uM. Although specific activity increased
and CelB2 was purified, only low levels of CelB2 were recovered. Future studies should aim to
further improve the procedure of CelB2 recovery, potentially through more stable variants of
CelB2 fusion protein or a better mutant of CelB2 itself.
Introduction
Cellulose, a plant polymer of D-glucose (bonded together by B-1,4-glucosyl linkages), is
the main component of plant cell walls and the most abundant protein in the world. It has largely](https://image.slidesharecdn.com/dcffc20f-5fec-4d6f-9e69-4c36b13967db-170113040613/85/Purification-Project-2-320.jpg)




![column volumes for a total of 30mL. A salt gradient of 0mM to 700mM NaCl was set up, and
fractions were collected at 1mL intervals, for a total of 38 elution fractions. Absorbance at
280nm was measured for each fraction.
A buffer exchange procedure similar to the previous mentioned buffer exchange was
carried out, constituting sodium phosphate buffer in place of piperazine.
End point activity assay and Bradford Assay
The activity assay was performed for the elution fractions, pre-digest, and the post-IEX
samples. 100uL of 1M substrate (pNPC: para-nitrophenyl -D-cellobioside ) was mixed with
100uL of protein containing fraction and incubated at 50°C for 30 minutes. Then, 0.1M NaOH
was added to halt the reaction. The solution was diluted with 800uL H2O and then absorbance
was read at 405nm. Calculations were done using extinction coefficient at 405nm = 18.1
mL/µmol/cm, in order to obtain concentration of [pNP] released.
A standard Bradford assay was carried out using Thermofisher’s Coomassie Protein
Assay Kit, with BSA protein as the standard, in order to measure concentration of protein in pre-
digest sample and post-IEX chromatography sample. Incubation for reaction occurred at room
temperature for 10 minutes. Absorbance was measured at 595nm.
Protein Concentration & Extinction Coefficient Determination
Absorbance at 280nm was measured for the protein sample after ion exchange
chromatography. Using Beer-Lamberts law, CelB2 concentration was obtained.
Using ExPASY Bioinformatics Resource Portal program ‘ProtParam’, the following
information was obtained using the Amino acid sequence for CelB2, which was later used in the
Beer-Lambert calculation for CelB2 concentration:](https://image.slidesharecdn.com/dcffc20f-5fec-4d6f-9e69-4c36b13967db-170113040613/85/Purification-Project-7-320.jpg)

![Figure 1: Plasmid restrictions of pMALc4CelB2 with EcoR I and Hind III were run on a 1%
agarose gel electrophoresis at 100V for 30 minutes. The first lane is a DNA ladder/marker. The
second lane is the uncut plasmid. The third lane is the single cut plasmid via EcoR I. The fourth
lane is the double cut plasmid (EcoR I and Hind III). The plasmid lanes were loaded on with
Orange G loading dye.
Based on the SDS-PAGE in Figure 2, the MW for CelB2-MBP was estimated to be
71.8kD using the equation and Rf values of the unknown protein as shown in Figure 3. This is
slightly different than what the estimated value would have been (65kd = 23kD [celB2] + 42kD
[mbp]). The R2 value isn’t at 0.99+ and thus may show that measurement errors for Rf values
could attest to the difference in 7kD reported. Changing the percent of the gel might help,
increasing it, to better create a linear line of fit.
Looking at the gel in Figure 2, pre-Induction had fewer proteins, and post-induction had
more proteins. Specifically, post-induction had CelB2 expressed. There is a thick band at the
same estimated MW value of 71.8kD. Comparing cell lysate and flow through, we can’t tell if
CelB2 is in those lanes in the gel or not since there are a large number of proteins all
throughout. Otherwise, it seems that CelB2 had successfully eluted from the column, as seen in
our elution fraction lanes.](https://image.slidesharecdn.com/dcffc20f-5fec-4d6f-9e69-4c36b13967db-170113040613/85/Purification-Project-9-320.jpg)



![Despite the results for the elution fractions shown in figure 5, the CelB2 activity assay
(table 3) was successful and shows activity. Table 3 shows that elution #26, labeled fraction #4,
has the highest concentration of pNP, and thus the highest activity of CelB2 based on this
activity assay, since every molecule of p-nitrophenol present means that one molecule of p-
nitrophenyl -D-cellobioside was broken down by CelB2. When combining elution fractions,
elution #26 was used, along with the two elutions around it (#25 & #27). A280 nm previously
showed highest absorbency for elution #14, but the activity assay shows that the protein
concentration was lowest in CelB2 for elution #14.
Additionally, since the activity assay (table 3) shows that CelB2 is present even though
CelB2 bands were not seen on the gel in figure 5, this helps us better understand the results
reported by the SDS-PAGE. CelB2 is present in the sample elution fractions, but the reason the
CelB2 band doesn’t show up on the SDS-PAGE may be because the concentration is far too
low. The calculations in table 3 support this possibility, since the concentrations determined are
less than 1umol. Because there is far more MBP recovered than CelB2 and their concentrations
are not comparable, there is a chance that CelB2 crashed out of solution. This step of the
experiment needs to be fine-tuned to produce comparable concentrations. Using a different
protease may be a solution.
Fraction # A405nm [pNP],umol
1 (14) 0.006 (0.006)/(18.1*1)= 0.0003/0.2 = 0.00165umol
2 (17) 0.026 0.026/(18.1*1) = 0.001436/0.2 = 0.00718umol
3 (21) 0.030 0.030/(18.1*1) = 0.001657/0.2 = 0.00828umol
4 (26) 1.075 1.075/18.1 = 0.0539/0.2 = 0.29696umol](https://image.slidesharecdn.com/dcffc20f-5fec-4d6f-9e69-4c36b13967db-170113040613/85/Purification-Project-13-320.jpg)

![Ion-Exchange
Absorbance
0.529 36.25ug/mL 36.25ug/mL *
1mg/1000ug =
0.03625mg/mL
Table 4: Calculations for [CelB2] in mg/mL for pre-digest and post-IEX samples, determined
using the Bradford Assay and the Bradford standard curve.
Procedure Total protein,
mg = total
volume (mL)
x protein
concentration
(mg/mL)
Total activity,
units
(experimental)
At 405nm
Specific
activity,
units/mg
protein
(calculate)
Yield, % Purification
fold
Amylose affinity
chromatography
(4 fractions) =
Pre-digest
4mL * .22125
mg/mL =
0.885mg
0.181 –
0.007(control)
= 0.174 units
0.174/0.885
= 0.1966
units/mg
100 1
DEAE Ion
exchange
chromatography
(3 fractions)
.300mL *
.03625
mg/mL =
0.01875mg
0.243 -
0.007(control)
= 0.236 units
0.236 /
0.01875 =
12.586
units/mg
0.236/0.174
*100 =
135.63%
12.586/0.1966
= 64.0183](https://image.slidesharecdn.com/dcffc20f-5fec-4d6f-9e69-4c36b13967db-170113040613/85/Purification-Project-15-320.jpg)
![Table 5: CelB2 purification: total protein, total activity, specific activity. Purification fold from pre-
digest of CelB2 solution to DEAE ion exchange chromatography is shown. Total protein and
specific activity are calculated.
We measure the A280nm value of the post-IEX sample of CelB2, and we use ExPASY
Bioinformatics Resource Portal program ‘ProtParam’ to determine the extinction coefficient for
the modified CelB2 in order to calculate the concentration of CelB2. We obtain 2.286uM of
CelB2.
A280 Path Length Extinction Coefficient [CelB2]
0.125 1cm 54680M-1 cm-1 (0.125)/(1*54680)=
2.286x10^-6 M = 2.286uM
Table 6: CelB2 concentration is determined using the Beer-lambert law, by use of Absorbance
at 280nm of the final protein solution purified from IEX.
We were unable to determine any information on the lysate sample since the sample
was lost, so we are unable to determine at what step the most protein was lost. Based on the
activity assay though, the purification fold was large (64x) from pre-digest to post-IEX
chromatography. Although this may support the idea that CelB2 was not lost greatly between
the steps, the total protein was far less for the IEX sample than it was for the pre-digest sample,
so a clear conclusion cannot be made. It is clear that not all of CelB2 was lost between the
steps since the activity fold showed an increase and not a decrease.
Overall, the protocol for expression was successful, but there were issues in CelB2
purification/recovery. There are too many steps where CelB2 can be lost, either significantly or
completely. Instead of needing to purify CelB2 through several separation techniques, it may be](https://image.slidesharecdn.com/dcffc20f-5fec-4d6f-9e69-4c36b13967db-170113040613/85/Purification-Project-16-320.jpg)